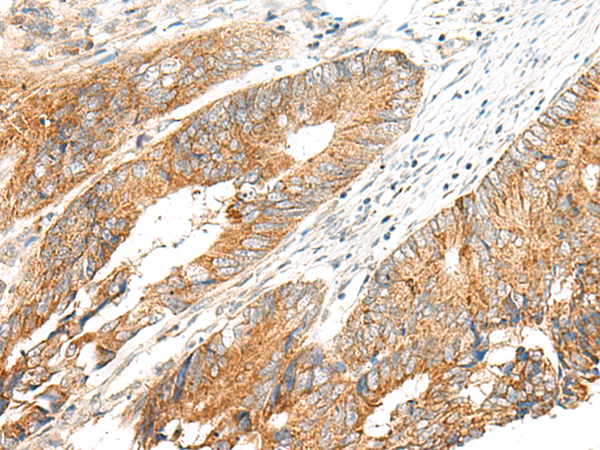
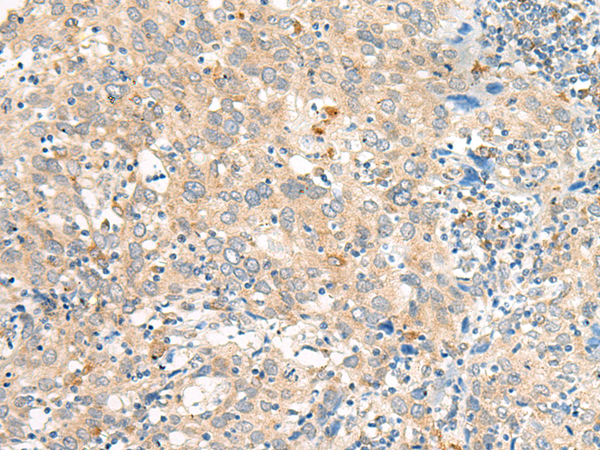
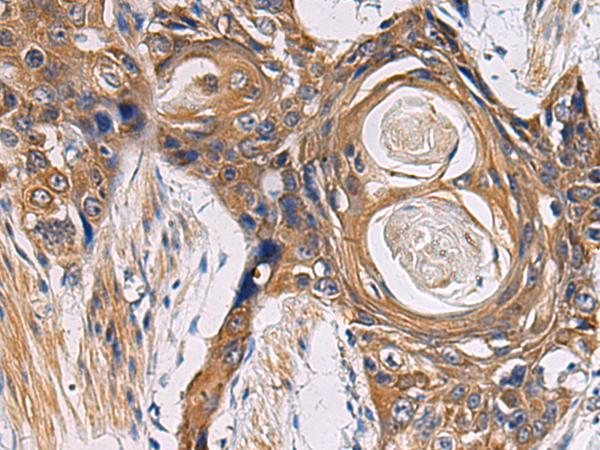

-
分类: 科研抗体货号: P06538别名:应用: IHC反应种属: Human, Mouse
-
分类: 科研抗体货号: P06537别名:应用: IHC反应种属: Human, Mouse
-
分类: 科研抗体货号: P06573别名: GDH; GDH1; GLUD应用: WB,IHC反应种属: Human, Mouse, Rat
-
分类: 科研抗体货号: P06536别名: PLB; CMD1P; CMH18应用: WB,IHC反应种属: Human, Mouse, Rat
-
分类: 科研抗体货号: P06604别名: S28; DBA15应用: WB,IHC反应种属: Human, Mouse, Rat
-
分类: 科研抗体货号: P06572别名: GLUT8; GLUTX1应用: IHC反应种属: Human, Mouse, Rat
-
分类: 科研抗体货号: P06590别名: GPCR2应用: WB,IHC反应种属: Human
-
分类: 科研抗体货号: P06599别名:应用: IHC反应种属: Human, Mouse
-
分类: 科研抗体货号: P06571别名: AMF; NLK; PGI; PHI; GNPI; SA36; SA-36应用: WB,IHC反应种属: Human, Mouse, Rat
-
分类: 科研抗体货号: P06589别名: P2Y14; BPR105; GPR105应用: IHC反应种属: Human

鄂公网安备42018502007531号
鄂公网安备42018502007531号

